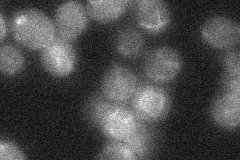
YMR101C
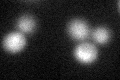
YMR101C
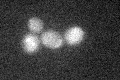
YMR101C

View description
Cis-prenyltransferase involved in synthesis of long-chain dolichols (19-22 isoprene units; as opposed to Rer2p which synthesizes shorter-chain dolichols); localizes to lipid bodies; transcription is induced during stationary phase
Localization:
Intensity:
Fold change:
Significance:
-
C’ GFP library in SD

below threshold15.93 -
N' NOP1pr-GFP in SD

punctate29.667 -
N' TEF2pr-mCherry in SD

punctate18.1151 -
N' NATIVEpr-GFP in SD
below threshold19.103 -
N' TEF2pr-VC and Cyto-VN in SD

punctate26.8373 -
C’ GFP library in SD+DTT
cytosol17.941.12No -
C’ GFP library in SD+H2O2
cytosol18.131.13No -
C’ GFP library in Starvation Media

cytosol18.351.15No -
C’ GFP library on the background of Pup2-DaMP

below threshold -
C’ GFP library on the background of CCT mutant

below threshold17.23531.08152No
